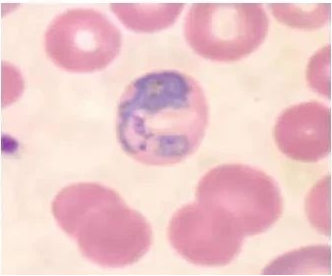
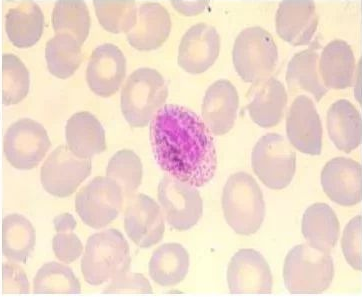
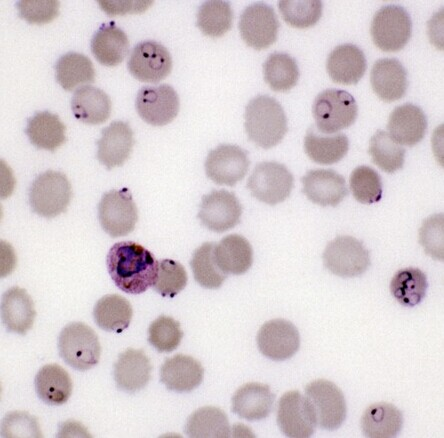
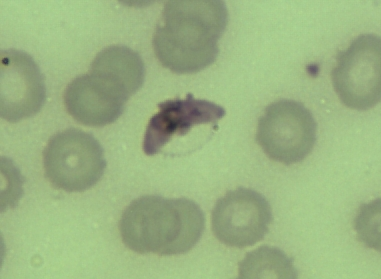
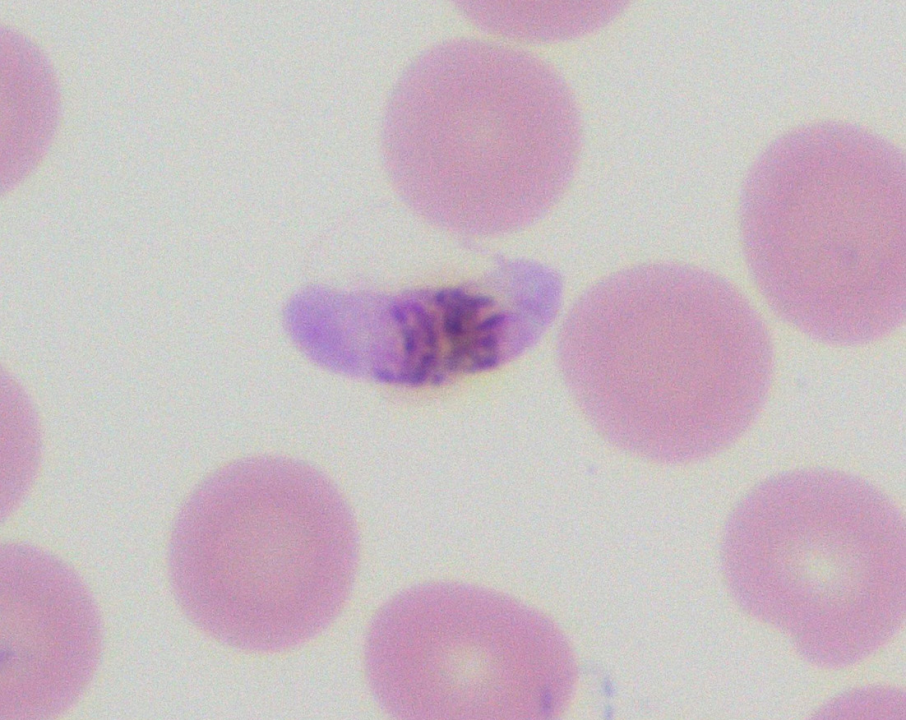

【案例】
患者,女,50岁,海南人,因近一周来表现间歇热而住院。
住院前4天,早晨体温正常,但下午发热(>38℃),发热前有寒战。晚上退热。住院前2天再次发作,症状同前。两次发作之间体温正常。在不发热期间,患者感觉良好,入院前经医师诊断为流行性感冒,经治疗无效,入院当天左侧胸痛,伴轻度咳嗽。先出现寒战,之后体温升至40.5℃而入院。入院后未服药,自行退热。
一般体检:患者急性病容。体温40.3℃,血压19.42/l1.97kPa(146/90mmHg),心率120次/分,呼吸20次/分。心脏检查正常,左肺可闻少量啰音,腹部检查正常。脾可触及、质软。
实验检查: 血红蛋白140g/L,红细胞沉降率14mm,白细胞总数6.65×109/L,其中中性粒细胞0.80,淋巴细胞0.20,尿糖及蛋白(-)。血涂片瑞特染色检查显示一个油镜视野中有4个红细胞内有原虫寄生,虫体均有一个细胞核和多量细胞质,细胞质形态不规则,有空泡和伪足,其上有棕黄色小点,被寄生的红细胞胀大、变浅,其上有红色小点。
【讨论】
1.该病人患的是什么疾病?
2.如何用病原学方法诊断该病?
3.治疗本病应注意哪些原则?
我国在疟疾防治中取得了伟大胜利
疟疾是危害全球人类健康的传染病。据世卫组织统计,2020年, 全球有90多个国家和地区有疟疾流行,病例总数为2.41亿例,死亡约62.7万人。我国曾经也是疟疾流行较为严重的国家。新中国成立前,每年约有3000万患者,病死率高达1%。新中国成立后,为保障人民群众的身体健康,上世纪50年代,我国开启了疟疾的防治工作。党中央领导全国人民积极抗击疟疾,发病人数明显下降。自2016年8月以来,我国再未发生本土感染的病例,从而实现了抗疟斗争的伟大胜利。2020年,我国向WHO申请了消除疟疾的正式认证,2021年6月30日,世界卫生组织宣布中国通过消除疟疾认证,称中国经过70年的不懈努力到如今完全消除疟疾是一项了不起的壮举。我国成为世卫组织西太平洋区域30多年来第一个获得无疟疾认证的国家。这是我国继天花、脊髓灰质炎、丝虫病、新生儿破伤风之后消除的又一重大传染病,结束了疟疾在我国长达数千年的历史,在全球消除疟疾史上具有重要的里程碑意义。